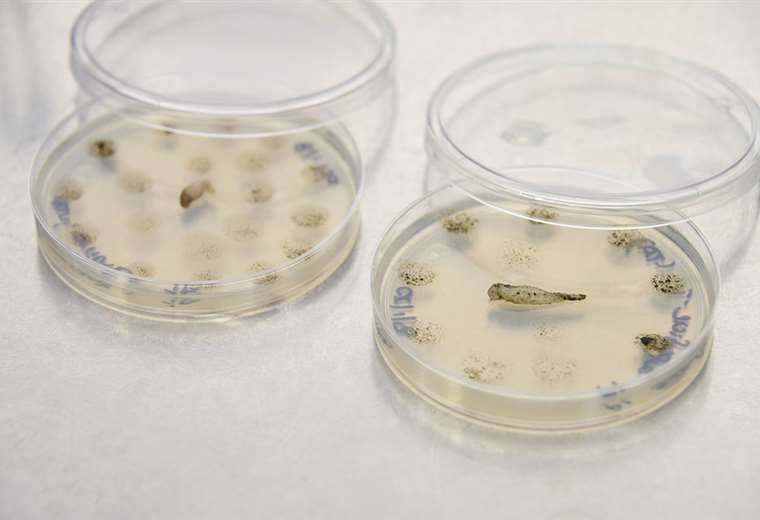

Científicas de la UCR buscan mortal ameba que mató a joven guanacasteco
A petición del Ministerio de Salud dos expertas en Parasitología lideran una investigación en aguas termales de Bagaces para tener certeza de la presencia de la Naegleria fowleri
Dos investigadoras de la facultad de Microbiología de la Universidad de Costa Rica buscan en balnearios de Bagaces la mortal ameba Naegleria fowleri, responsable de la muerte de un joven guanacasteco el pasado 7 de enero en Liberia.
Las doctoras Elizabeth Abrahams y Lissette Retana, del departamento de Parasitología de la UCR, encabezan una investigación de campo en nueve piscinas y nacientes de aguas termales de centros turísticos en Guayabo de Bagaces (donde se infectó el joven) para tener certeza de la presencia de la ameba en esos lugares.
“La UCR realizó el muestreo en nueve piscinas y nacientes de aguas termales de Guanacaste el 08 de enero de 2020. De cada piscina se sacaron cinco litros para un total de 45 recolectados. Esta labor se hizo en compañía de tres funcionarios del ministerio”, afirmó Abrahams.
La investigación precisamente se realiza a petición del Ministerio de Salud y tuvo además un proceso de análisis y muestreo de zonas cercanas a los balnearios, incluida la tierra, para buscar organismos que habitan alrededor del agua.
Las muestras ya están siendo procesadas en el laboratorio y estarán sujetas a estrictas pruebas. Los resultados finales se obtendrán después de un mínimo de 15 días.
“Con la aplicación de los ensayos, primero buscaremos la ameba y, si los resultados salen positivos, se procederá a confirmar a nivel molecular que sea de la especie fowleri. Nuestros reportes van a indicar si se observan o no amebas en el agua recolectada en ese momento. En caso de que no se observen en la muestra, no se descarta la presencia de la N. fowleri en las piscinas”, dijo Abrahams.
Esto significa que aunque los resultados sean negativos la presencia de la ameba no puede descartarse, pues la muerte del menor es una certeza a nivel epidemiológico, por lo que la eventual ausencia en las pruebas de laboratorio podría significar que el microorganismo podría estar en pocas cantidades.
En ese último caso la UCR reiteró que, aún en ausencia de amebas, las piscinas de agua termal siempre serán un sitio adecuado para que la N. fowleri prolifere.
“A menor número de esta ameba es más difícil aislarla. Por lo tanto, lo importante aquí es enfatizar que, a nivel epidemiológico, se sabe que el niño se infectó en esa zona. Por otro lado, si el resultado es positivo a nivel molecular, se respalda más el hecho de ese lugar como punto de infección. Independientemente del resultado, la información es necesaria para fortalecer las acciones de vigilancia y de prevención”, añadió la especialista.
¿Por qué es tan mortal?
La Naegleria fowleri es un microorganismo capaz de vivir y replicarse en el medio ambiente sin necesidad de un huésped, además, puede subsistir hasta en los ambientes más inhóspitos y reproducirse de manera rápida.
Se alimenta de bacterias de su entorno, pero si no las encuentra se comporta como un parásito para asegurar su subsistencia.
Esto significa que aunque es muy difícil que una persona la adquiera (se presenta un caso en 2.5 millones), cuando esto sucede la ameba se reproduce rápidamente en el cuerpo, haciendo que para el sistema inmunológico la lucha sea prácticamente imposible.
“Este tipo de situación es tan infrecuente en el país, que cuesta mucho que los médicos y los laboratorios hospitalarios estén atentos a considerar un diagnóstico diferencial. Entonces, a nivel mundial, y no solo en Costa Rica, hablamos de que hay probablemente un subregistro e, incluso, una falta de publicación de los casos”, enfatizó la Dra. Abrahams.
Cuando la N. fowleri ingresa al cuerpo, lo que hace es viajar por las vías nasales en busca de alimento. Como no encuentra bacterias para consumir, la única opción que tiene es subir, atravesar una barrera ósea conocida como placa clinoide y alojarse en el cerebro.
Casi inmediatamente después de su ingreso, la ameba inicia un proceso de meningitis (infección de las membranas que rodean el cerebro y la médula espinal) divido en dos etapas: La primera es un severo dolor de cabeza frontal, fiebre, naúseas y vómitos, la segunda se caracteriza por rigidez en el cuello, convulsiones, estado mental alterado, alucinaciones y el coma.
En promedio, el proceso infeccioso dura 15 días, o menos, antes de una muerte que médicos y científicos describen como “aguda y fulminante”.
“La evidencia señala que la ameba lo que hace es destruir las neuronas por fagocitosis, que es cuando su membrana rodea las partículas sólidas y las introduce en su interior. También, la ameba puede inducir la muerte celular por contacto. Con esto último, ella luego absorbe los fragmentos de la célula”.
“Ahora bien, lo que causa la muerte del paciente es el proceso inflamatorio que origina la presencia de un microorganismo que no debería estar ahí. El cerebro y las meninges son muy sensibles a ese proceso, por lo que causa mucho daño al tejido y la muerte”, explicó el Dr. Fernando García Santamaría, vicerrector de Investigación de la UCR.
La Dra. Abrahams insistió que las aguas termales son para descansar, no para saltar, nadar o sumergirse. También, recalcó el uso de nariceras y la importancia que los centros turísticos realicen de manera más frecuente la limpieza de sus piscinas.
“El sitio se puede acondicionar con piscinas de agua clorada para que los niños se diviertan, y al lado tener piscinas de agua termal para que cumplan su función de descanso”, aconsejó la especialista.